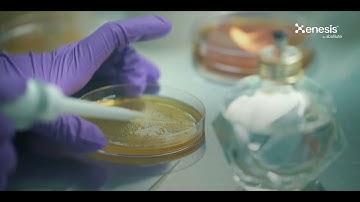
Xenesis | Taking Humanity Forward

⬇ DOWNLOAD NOW
Kalau muncul iklan pop-up, tutup lalu klik tombol kembali
Download lagu Simulating Exoplanet Transits with ExoTransit (Featuring Sonification for Accessibility) secara gratis hanya untuk keperluan promosi. Dukung artis favorit kamu dengan membeli musik original di iTunes atau platform resmi lainnya.
 Access Automated Science Expertise, Avoid Risks, and Protect Nature & Biodiversity.
Access Automated Science Expertise, Avoid Risks, and Protect Nature & Biodiversity.
 Exoplanet Transit Photometry: Unlocking New Frontiers with Miniature Instruments
Exoplanet Transit Photometry: Unlocking New Frontiers with Miniature Instruments
 Detecting Exoplanets With the Transit Method
Detecting Exoplanets With the Transit Method
 Autonomous Agile Earth Imaging with Intent Sharing
Autonomous Agile Earth Imaging with Intent Sharing
 What Is an Exoplanet?
What Is an Exoplanet?
 New Constellations of Satellites | See Yourself in Space
New Constellations of Satellites | See Yourself in Space
Xenesis | Taking Humanity Forward
Xenesis | Taking Humanity Forward
 OBSERVER Trailer 🟥 There's a universe everywhere you turn.
OBSERVER Trailer 🟥 There's a universe everywhere you turn.